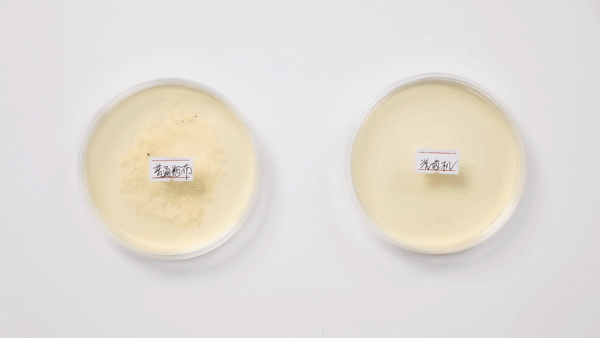
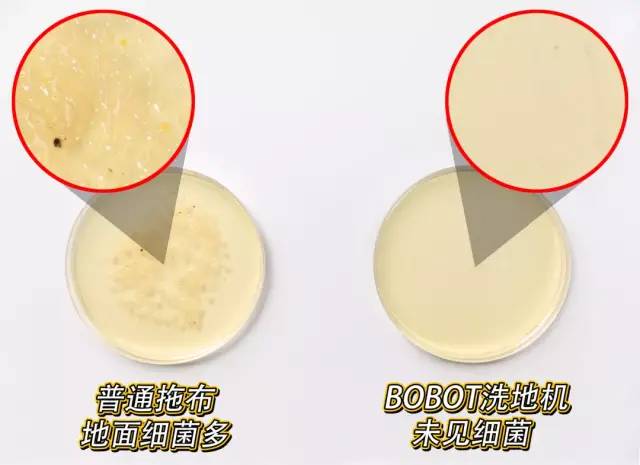

娱乐圈的明星们是怎么打扫卫生的?
2021年01月06日

长期抹地时弯腰
导致的。

地板缝隙平均细菌数甚至达到医院细菌的7倍。
可是,使用杀菌液、消毒水杀菌,刺鼻又不安全。

BOBOT洗地机
可以告诉你答案。
吸地、扫地、拖地、杀菌轻松搞定。
跟它一比,吸尘器和扫地机器人都弱爆了!







谢娜、李湘、刘涛,以及景甜、张静初、刘维
众多明星都在推荐!

可省下7000多块钱!而且使用起来无需弯腰,
轻轻松松把家里打扫干净。

官方旗舰店售价3660元,
而我们今天直接带来了直降761元的优惠价格!

机
自身拥有5Kpa强大地面吸力,
可以将毛发、饼干渣各种干垃圾轻松吸走。


5KPa地面吸力,连湿垃圾都秒吸掉
░
“生活垃圾灾难现场”
进行真实使用。



「洗」过的地面,超级干净~

它的拖地功能与普通拖布存在本质区别。

设计了净水箱和污水箱两个水箱,
同时设计双孔活水系统,让清水箱出水拖地,
污水箱进行污水回收。



可以向清水箱中加入一些附赠的清洁液。




机身底部设置了UV智能灭菌灯带,
利用紫外线照射进行杀菌,不伤地板,无毒无害,
比杀菌液、消毒水擦地更安全。

杀菌率高达99%。

一个细菌检测实验
告诉你,
你家的地板多脏、拖布有多“不靠谱”!

普通拖布拖过的地面居然有这么多细菌,而且还有一股臭味!
不伤地板,也不会刺鼻。



缩短清洁时间,提升清洁效率。










无需频繁加水,省了不少事。






可以对滚刷进行自动清洁。







BOBOT洗地机更加省水,清水箱里的水更加耐用。







一下子就将青菜吸进了污水
处理箱。





轻松打扫完一间屋子。

对地毯进行日常清洁维护。

吸地面的头发、狗狗毛发
的话,无需在清水箱中加水,直接吸走就OK。


从使用习惯入手,将智能更巧妙的运用到地面清洁中。
、
会杀菌的BOBOT洗地机。


杀菌功能,使用起来更让人放心。

而且操作简单,上年纪的长辈也上手就会。

地机在
官方旗舰店售价3660元,
而我们今天带来了直降761元的优惠价格!


BOBOT洗地机等于吸尘器+拖地机+扫地机+地面杀菌仪
,还省时不费力,这笔帐怎么算都合适。


473阅读
6赞
普象好用
已同步到看一看
写下你的想法